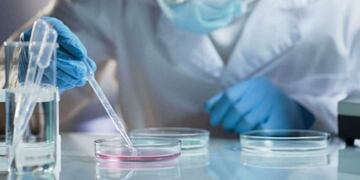
Coronavirus\u002E

Vía País
El Riesgo País sigue en caída y vuelven a subir con fuerza los bonos
La tendencia continúa bajista, a pesar de la negativa de tres de los grupos que representan a los principales bonistas ante la propuesta de reestructuración de deuda que anunció el Gobierno.